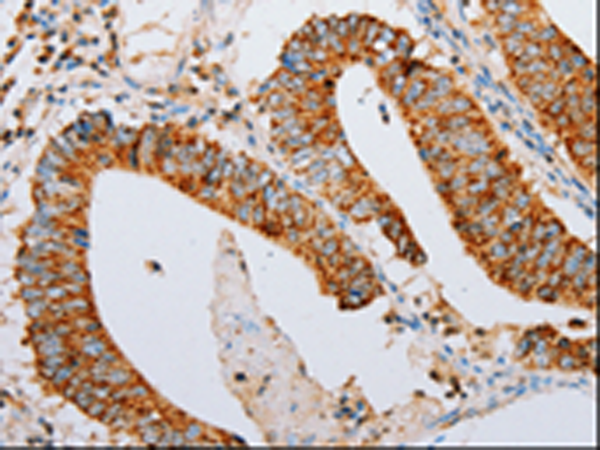

-
分类: 科研抗体货号: P10642别名: YT; ACEE; ARACHE; N-ACHE应用: WB,IHC反应种属: Human, Mouse, Rat
-
分类: 科研抗体货号: P10687别名: TC4, Gsp1, ARA24应用: WB,IHC反应种属: Human, Mouse, Rat
-
分类: 科研抗体货号: P10671别名: RAL应用: WB,IHC反应种属: Human, Mouse, Rat
-
分类: 科研抗体货号: P10683别名:应用: WB,IHC反应种属: Human, Mouse, Rat
-
分类: 科研抗体货号: P10692别名: BMP-3A应用: WB,IHC反应种属: Human
-
分类: 科研抗体货号: P10670别名:应用: WB,IHC反应种属: Human, Mouse, Rat
-
分类: 科研抗体货号: P10682别名: CKMM, M-CK应用: WB,IHC反应种属: Human, Mouse, Rat
-
分类: 科研抗体货号: P10691别名: TFQTL1应用: WB反应种属: Human
-
分类: 科研抗体货号: P10705别名: ACVR2, ACTRII应用: WB,IHC反应种属: Human, Mouse, Rat
-
分类: 科研抗体货号: P10680别名: GPBB应用: WB反应种属: Human, Mouse, Rat

鄂公网安备42018502007531号
鄂公网安备42018502007531号

